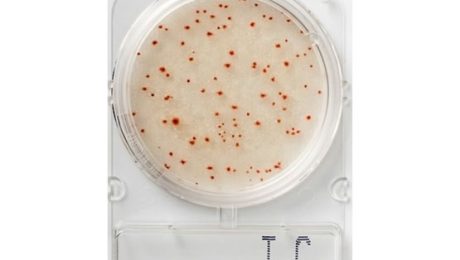

Nissui Compact Dry için on ikinci sertifika
Salı, 31 Mayıs 2022
- Published in Blog, Uncategorized
No Comments
Lumitester Smart, iF DESIGN AWARD 2021’i kazandı
Cuma, 04 Haziran 2021
- Published in Blog, Uncategorized